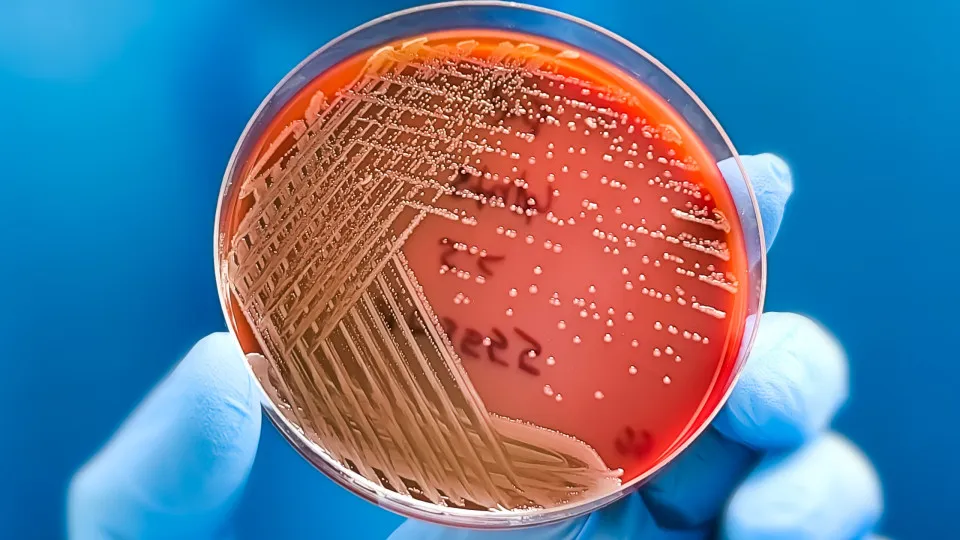

Uma equipa de investigadores converteu moléculas do fungo tóxico 'Aspergillus flavus', que infeta grãos como o milho e a soja e tem sido associado a mortes em escavações de túmulos antigos, num promissor composto anticancerígeno.
Liderada por cientistas da Universidade da Pensilvânia, nos Estados Unidos, a equipa modificou algumas das moléculas do fungo e testou-as com células leucémicas.
O resultado, divulgado hoje na revista científica Nature Chemical Biology, foi um composto contra o cancro que abre caminho à descoberta de mais medicamentos com origem em fungos.
"Os fungos deram-nos a penicilina. Agora, estes novos resultados mostram-nos que muitos outros medicamentos derivados de produtos naturais ainda estão por descobrir", sublinha Sherry Gao, professora de bioengenharia na Universidade da Pensilvânia e autora sénior do estudo, citada pela agência noticiosa espanhola EFE.
Leia Também: Teste revolucionário pode detetar cancro três anos antes dos sintomas
O 'Aspergillus flavus' é há muito conhecido como microrganismo patogénico, sendo associado à designada "maldição de Tutankhamon", o faraó cujo túmulo foi aberto na década de 1920 por uma equipa de arqueólogos, tendo vários dos que participaram na escavação tido mortes prematuras.
Décadas mais tarde, os médicos teorizaram que os esporos de fungos, adormecidos durante milénios, podem ter desempenhado um papel nas mortes, que voltaram a acontecer, na década de 1970, depois de uma dúzia de cientistas ter entrado no túmulo de Casimiro IV da Polónia.
Em poucas semanas 10 deles morreram e investigações posteriores revelaram que o túmulo continha 'A. flavus', cujas toxinas podem causar infeções pulmonares.
A terapia em causa utiliza RiPPs, ribosomally synthesized and post-translationally modified peptides (peptídeos sintetizados por ribossomas e modificados pós-translação). O composto é produzido pelo ribossoma, uma pequena estrutura celular que produz proteínas, e é posteriormente modificado, neste caso, para melhorar as suas propriedades anticancerígenas.
"Purificar estas substâncias químicas é difícil", explica Qiuyue Nie, investigadora de pós-doutoramento na Universidade Estadual da Pensilvânia e primeira autora do artigo, segundo a EFE.
Para encontrar RiPPs fúngicas (apenas algumas foram encontradas até agora), os investigadores analisaram primeiro uma dúzia de estirpes de 'Aspergillus', que pesquisas anteriores sugeriam poder conter mais destas substâncias químicas, tendo identificaram o 'A. flavus' como um candidato promissor para estudos mais aprofundados.
A nova abordagem utilizada, combinando informação metabólica e genética, não só identificou a fonte das RiPPs fúngicas no 'A. flavus', como também pode ser utilizada para encontrar mais RiPPs fúngicas no futuro.
Após purificarem quatro RiPPs diferentes, os investigadores descobriram que as moléculas partilhavam uma estrutura única de anéis interligados, a que chamaram "asperigimicinas", tendo duas das quatro variantes demonstrado potencial medicinal quando misturadas com células leucémicas.
Através de experiências adicionais, os investigadores descobriram que as "asperigimicinas" provavelmente interrompem o processo de divisão celular.
"As células cancerígenas dividem-se de forma descontrolada. Estes compostos bloqueiam a formação de microtúbulos, essenciais para a divisão celular", explica Gao.
Os compostos tiveram pouco ou nenhum efeito em células de cancro da mama, fígado ou pulmão, sugerindo que os efeitos disruptivos das "asperigimicinas" são específicos para certos tipos de células.
O passo seguinte é testar as "asperigimicinas" em modelos animais, esperando que um dia se possam realizar testes clínicos em humanos.
Leia Também: Especialistas alertam sobre cancro raro que quadruplicou nos jovens